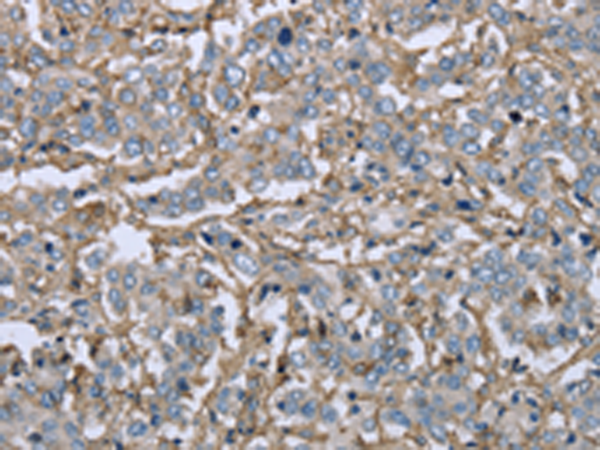

-
分类: 科研抗体货号: P08326别名: FHF4; FHF-4; SCA27; FGF-14应用: WB反应种属: Human
-
分类: 科研抗体货号: P08348别名: FUCA应用: WB,IHC反应种属: Human, Mouse
-
分类: 科研抗体货号: P08325别名: HH20; FGF-13应用: WB反应种属: Human, Mouse, Rat
-
分类: 科研抗体货号: P08346别名: FRP; FSL1; MIR198应用: IHC反应种属: Human, Mouse, Rat
-
分类: 科研抗体货号: P08324别名: FPS应用: IHC反应种属: Human, Mouse
-
分类: 科研抗体货号: P08345别名: GTK; RAK; PTK5应用: WB,IHC反应种属: Human, Mouse, Rat
-
分类: 科研抗体货号: P08323别名: CD89应用: WB,IHC反应种属: Human
-
分类: 科研抗体货号: P08342别名: EWSR2; SIC-1; BDPLT21应用: WB反应种属: Human, Mouse
-
分类: 科研抗体货号: P08322别名: CD32; FCG2; CD32B; FCGR2; IGFR2应用: WB,IHC反应种属: Human
-
分类: 科研抗体货号: P08341别名: BHD; FLCL应用: IHC反应种属: Human, Mouse, Rat

鄂公网安备42018502007531号
鄂公网安备42018502007531号

